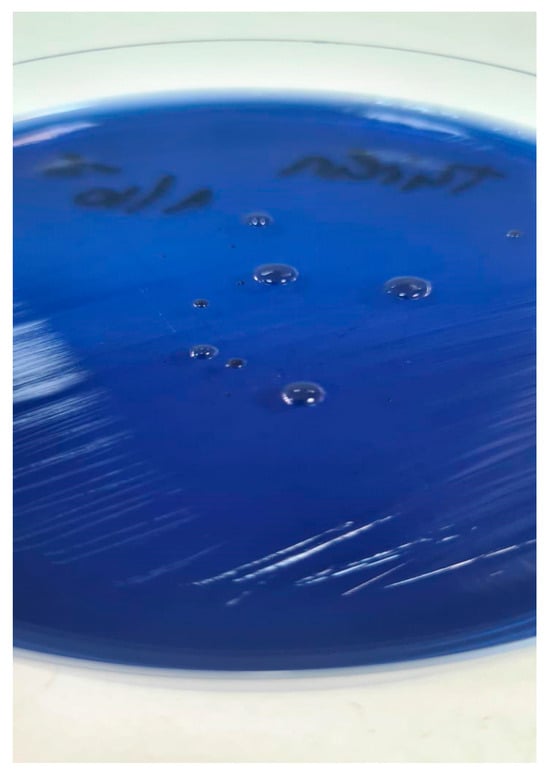

Journal Description
Life
Life
is an international, peer-reviewed, open access journal of scientific studies related to fundamental themes in life sciences, from basic to applied research, published monthly online by MDPI. The Astrobiology Society of Britain (ASB) and Spanish Association for Cancer Research (ASEICA) are affiliated with Life and their members receive a discount on the article processing charges.
- Open Access— free for readers, with article processing charges (APC) paid by authors or their institutions.
- High Visibility: indexed within Scopus, SCIE (Web of Science), PubMed, PMC, CAPlus / SciFinder, and other databases.
- Journal Rank: JCR - Q1 (Biology) / CiteScore - Q1 (Paleontology)
- Rapid Publication: manuscripts are peer-reviewed and a first decision is provided to authors approximately 19.3 days after submission; acceptance to publication is undertaken in 2.6 days (median values for papers published in this journal in the first half of 2025).
- Recognition of Reviewers: reviewers who provide timely, thorough peer-review reports receive vouchers entitling them to a discount on the APC of their next publication in any MDPI journal, in appreciation of the work done.
- Testimonials: See what our editors and authors say about Life.
- Companion journals for Life include: Physiologia and Hydrobiology.
Impact Factor:
3.4 (2024);
5-Year Impact Factor:
3.4 (2024)
Latest Articles
An Innovative Pubic Symphyseal Plate for the Treatment of Open-Book Injury: A Biomechanical Feasibility Study
Life 2025, 15(11), 1708; https://doi.org/10.3390/life15111708 - 4 Nov 2025
Abstract
(1) Background: This study proposes investigating the biomechanical stability of a novel 6-hole L-shaped plate for symphyseal fixation, which allows for reduction and stability in two planes. The results of the novel plate are compared to the standard plate; (2) Methods: The novel
[...] Read more.
(1) Background: This study proposes investigating the biomechanical stability of a novel 6-hole L-shaped plate for symphyseal fixation, which allows for reduction and stability in two planes. The results of the novel plate are compared to the standard plate; (2) Methods: The novel plate fixation and the standard 6-hole pubic symphyseal plate were tested with a pelvis model simulating an APC III injury. Each group of 10 pelves was subjected to a cyclic biomechanical single-leg-stance test for 30,000 cycles simulating partial bearing loading at 1 Hz, followed by a maximum load-to-failure test. The stiffness and displacement were evaluated and analyzed; (3) Results: Stiffness measurements during cyclic loading revealed no significant differences between the groups (p = 0.514). The cumulative plastic deformation was significantly lower in the novel plate group (p = 0.005). Load-to-failure testing demonstrated that both constructs exhibited similar ultimate strength, with no significant difference in the mean of maximum force between the novel (400.61 ± 44.65 N) and reference (433.02 ± 87.60 N) groups (p = 0.804); (4) Conclusions: The novel plate provides comparable biomechanical stability to the reference plate under the tested cyclic loading conditions, suggesting that it could be a viable alternative to the existing standard. However, further research is necessary to understand the clinical outcomes and long-term impacts.
Full article
(This article belongs to the Section Medical Research)
►
Show Figures
Open AccessArticle
Protective Anti-Inflammatory and Antioxidant Mechanisms of Ohwia caudata Leaf Hydroethanolic Extract in a Dermatitis Mouse Model
by
Tzu-Kai Lin, Bruce Chi-Kang Tsai, Shih-Wen Kao, Chia-Lun Tsai, Chia-Hua Kuo, Tsung-Jung Ho, Dennis Jine-Yuan Hsieh, Shinn-Zong Lin, Wei-Wen Kuo and Chih-Yang Huang
Life 2025, 15(11), 1707; https://doi.org/10.3390/life15111707 - 4 Nov 2025
Abstract
Contact dermatitis is a common inflammatory skin disorder characterized by erythematous and pruritic lesions caused by irritant exposure. Ohwia caudata, a traditional medicinal plant, possesses anti-inflammatory and antioxidant properties, but its dermatoprotective potential remains unclear. To investigate the protective effects and mechanisms
[...] Read more.
Contact dermatitis is a common inflammatory skin disorder characterized by erythematous and pruritic lesions caused by irritant exposure. Ohwia caudata, a traditional medicinal plant, possesses anti-inflammatory and antioxidant properties, but its dermatoprotective potential remains unclear. To investigate the protective effects and mechanisms of Ohwia caudata leaves’ hydroethanolic extract in a murine model of TPA-induced contact dermatitis. Major phytochemicals in Ohwia caudata extract were identified by HPLC–MS. SKH1/J hairless mice were topically treated with Ohwia caudata extract following TPA stimulation. Skin barrier function was assessed by transepidermal water loss and hydration. Inflammatory (IL-6, TNF-α, TGF-β), antioxidant (SIRT1, Nrf2, HO-1), and ERK-related (p-ERK, eIF2α, ATF-4, CHOP) proteins were analyzed by immunoblotting and immunofluorescence. HPLC–MS revealed harmine, swertisin, isoliquiritigenin, eupatilin, 3′,4′-dimethoxyflavone, and nerolidol as key constituents. The extract significantly reduced transepidermal water loss and enhanced hydration, indicating improved barrier integrity. It downregulated IL-6 and TNF-α while restoring TGF-β expression. ERK and downstream eIF2α/ATF-4/CHOP activation were suppressed, whereas SIRT1/Nrf2/HO-1 antioxidant signaling was enhanced. Ohwia caudata leaves hydroethanolic extract protects against TPA-induced dermatitis by improving skin barrier function, suppressing inflammation, and activating antioxidant defense, supporting its potential as a natural therapeutic for inflammatory skin diseases.
Full article
(This article belongs to the Section Physiology and Pathology)
►▼
Show Figures

Figure 1
Open AccessArticle
PICU Face and Thoracoabdominal Detection Using Self-Supervised Divided Space–Time Mamba
by
Mohamed Khalil Ben Salah, Philippe Jouvet and Rita Noumeir
Life 2025, 15(11), 1706; https://doi.org/10.3390/life15111706 - 4 Nov 2025
Abstract
Non-contact vital sign monitoring in Pediatric Intensive Care Units is challenged by frequent occlusions, data scarcity, and the need for temporally stable anatomical tracking to extract reliable physiological signals. Traditional detectors produce unstable tracking, while video transformers are too computationally intensive for deployment
[...] Read more.
Non-contact vital sign monitoring in Pediatric Intensive Care Units is challenged by frequent occlusions, data scarcity, and the need for temporally stable anatomical tracking to extract reliable physiological signals. Traditional detectors produce unstable tracking, while video transformers are too computationally intensive for deployment on resource-limited clinical hardware. We introduce Divided Space–Time Mamba, an architecture that decouples spatial and temporal feature learning using State Space Models to achieve linear-time complexity, over 92% lower than standard transformers. To handle data scarcity, we employ self-supervised pre-training with masked autoencoders on over 50 k domain-specific video clips and further enhance robustness with multimodal RGB-D input. Our model demonstrates superior performance, achieving 0.96 mAP@0.5, 0.62 mAP50-95, and 0.95 rotated IoU. Operating at 23 FPS (43 ms latency), our method is approximately 1.9× faster than VideoMAE and 5.7× faster than frame-wise YOLOv8, demonstrating its suitability for real-time clinical monitoring.
Full article
(This article belongs to the Special Issue Current and Future Perspectives of Artificial Intelligence in Medicine)
►▼
Show Figures

Figure 1
Open AccessReview
Understanding Drug Permeability in Pseudomonas aeruginosa
by
Ishan Ghai
Life 2025, 15(11), 1705; https://doi.org/10.3390/life15111705 - 4 Nov 2025
Abstract
Pseudomonas aeruginosa is a Gram-negative bacterium that poses a serious threat to patients with weakened immunity, cystic fibrosis, severe burns, or those in hospitals. Its ability to resist antibiotics comes largely from its outer membrane, which blocks drug entry. This means higher doses
[...] Read more.
Pseudomonas aeruginosa is a Gram-negative bacterium that poses a serious threat to patients with weakened immunity, cystic fibrosis, severe burns, or those in hospitals. Its ability to resist antibiotics comes largely from its outer membrane, which blocks drug entry. This means higher doses are often needed, raising the risk of side effects. To design new treatments, researchers need drugs that not only bind strongly to bacterial targets but also cross this tough membrane. Unfortunately, there are few reliable methods to directly measure how easily drugs pass through the Pseudomonas aeruginosa cell envelope. Recent advances, such as electrophysiology-based flux studies, have started to reveal how different antibiotics particularly β-lactams move through porin channels. These studies show large differences in permeability, but the findings remain scattered. What is missing is a unified dataset that captures permeability under varied conditions. Such a resource would clarify how porin structures influence drug entry and help chemists design better compounds. This review brings together current knowledge on drug permeability in Pseudomonas aeruginosa, with a focus on electrophysiological and related methods. This review highlights the need for standardized approaches that generate consistent and comparable data. A comprehensive “permeability atlas” could guide the development of new antibiotics by fine-tuning molecular properties like size, charge, and lipophilicity, ultimately improving porin passage and restoring treatment effectiveness against this challenging pathogen.
Full article
(This article belongs to the Special Issue Bacterial Antibiotic Resistance: From Mechanisms to Strategies for Restoring Antibiotic Efficacy)
►▼
Show Figures

Figure 1
Open AccessArticle
Effect of Early Extracorporeal Shockwave Therapy on Postoperative Pain and Functional Recovery After Intramedullary Nailing: An Open-Label Randomized Controlled Trial
by
Yonghyun Yoon, Jihyo Hwang, Jaeyoung Lee, King Hei Stanley Lam, Jeimylo C. de Castro, Hyeongjik Kim, Dongyeun Sung, Seungbeom Kim, MinJae Lee and Chanwool Park
Life 2025, 15(11), 1704; https://doi.org/10.3390/life15111704 - 3 Nov 2025
Abstract
Background/Objectives: Intramedullary (IM) nailing for hip fractures can cause iatrogenic abductor muscle injury, leading to pain and functional impairment. This study evaluated whether early extracorporeal shockwave therapy (ESWT) safely accelerates recovery. Methods: In this open-label randomized controlled trial, 51 patients (≥50 years; intention-to-treat:
[...] Read more.
Background/Objectives: Intramedullary (IM) nailing for hip fractures can cause iatrogenic abductor muscle injury, leading to pain and functional impairment. This study evaluated whether early extracorporeal shockwave therapy (ESWT) safely accelerates recovery. Methods: In this open-label randomized controlled trial, 51 patients (≥50 years; intention-to-treat: ESWT n = 26; control n = 25) received either standard postoperative care (control) or standard care plus three ESWT sessions. The primary outcome was pain (Visual Analog Scale, VAS); the secondary outcome was hip function (modified Harris Hip Score, mHHS), assessed at 3, 6, and 12 months. Results: Linear mixed-effects modeling showed significantly faster pain reduction in the ESWT group (group × time β = 0.086 points/month; p = 0.027), corresponding to an additional 1.0-point VAS reduction over 12 months. Functional improvement (mHHS) did not reach statistical significance (group × time β = 0.485; p = 0.462). No ESWT-related adverse events were observed. Conclusions: Early postoperative ESWT is a safe adjunctive therapy that accelerates pain relief after IM nailing for hip fractures. Although functional improvements were not statistically significant, pain reduction may facilitate early mobilization and rehabilitation.
Full article
(This article belongs to the Special Issue Recent Advances in Shockwave Therapy for Musculoskeletal and Soft-Tissue Disorders)
►▼
Show Figures

Figure 1
Open AccessArticle
Anti-IL-17 and Anti-IL-23 Therapies Modulate Serum Biomarkers of Intestinal Dysbiosis and Oxidative Stress Linked to Cardiovascular Risk in Patients with Psoriasis
by
Giuseppe Annunziata, Emanuele Scala, Laura Mercurio, Luca Sanna, Anna Dattolo, Gianluca Pagnanelli, Maria Grazia Lolli, Roberta Belli, Gaia Moretta, Silvia Savastano, Giovanna Muscogiuri, Maria Maisto, Roberto Ciampaglia, Vincenzo Piccolo, Gian Carlo Tenore, Cristina Albanesi, Stefania Madonna and Luigi Barrea
Life 2025, 15(11), 1703; https://doi.org/10.3390/life15111703 - 3 Nov 2025
Abstract
Psoriasis is a chronic inflammatory skin disease whose pathogenesis involves not only cutaneous inflammation but also intestinal dysbiosis and oxidative stress (OxS). Monoclonal antibodies targeting interleukin (IL)-17 and IL-23 have demonstrated significant immunomodulatory effects; however, their impact on systemic parameters requires further investigation.
[...] Read more.
Psoriasis is a chronic inflammatory skin disease whose pathogenesis involves not only cutaneous inflammation but also intestinal dysbiosis and oxidative stress (OxS). Monoclonal antibodies targeting interleukin (IL)-17 and IL-23 have demonstrated significant immunomodulatory effects; however, their impact on systemic parameters requires further investigation. We conducted a study on 33 patients with plaque psoriasis treated with anti-IL-17 or anti-IL-23 monoclonal antibodies. Dermatological parameters (Psoriasis Area and Severity Index (PASI) and Dermatology Life Quality Index (DLQI)), biomarkers of intestinal dysbiosis (trimethylamine-N-oxide (TMAO)) and OxS (reactive oxygen metabolites (d-ROMs) and oxidized LDL (oxLDL)) were evaluated. Anthropometric, metabolic, and adipose-derived hormonal parameters (adipokines) were also monitored. After 16 weeks of therapy, significant improvements were observed in PASI and DLQI scores (p < 0.001). TMAO levels were significantly reduced (p = 0.02), as were d-ROMs and oxLDL (p < 0.001). No significant changes were found in weight, body mass index, lipid profile, or adipokine levels (visfatin, leptin and adiponectin). Our data indicate that monoclonal antibody therapy not only improves psoriasis severity but also exerts beneficial effects on systemic biomarkers of dysbiosis and OxS, independent of metabolic or hormonal changes. These findings suggest a systemic mechanism of action, supporting a multifactorial therapeutic effect with potential implications for the prevention of cardiovascular risk.
Full article
(This article belongs to the Special Issue Skin Diseases and Dermatologic Comorbidities)
►▼
Show Figures

Figure 1
Open AccessArticle
Comparison of Triglyceride-Glucose Index Indices and Fatty Liver Index in Predicting Metabolic Dysfunction-Associated Fatty Liver Disease: A Cross-Sectional Study Conducted in Vietnam
by
Linh Nhat Boi Nguyen and Thong Duy Vo
Life 2025, 15(11), 1702; https://doi.org/10.3390/life15111702 - 3 Nov 2025
Abstract
Background and Aims: Metabolic dysfunction-associated fatty liver disease (MAFLD) is increasingly prevalent and linked to liver and cardiometabolic complications. Although liver biopsy remains the diagnostic gold standard, its invasiveness limits routine use, and imaging modalities show variable accuracy. Non-invasive indices such as triglyceride-glucose
[...] Read more.
Background and Aims: Metabolic dysfunction-associated fatty liver disease (MAFLD) is increasingly prevalent and linked to liver and cardiometabolic complications. Although liver biopsy remains the diagnostic gold standard, its invasiveness limits routine use, and imaging modalities show variable accuracy. Non-invasive indices such as triglyceride-glucose (TyG), triglyceride glucose-body mass index (TyG-BMI), triglyceride glucose-waist circumference (TyG-WC), and the fatty liver index (FLI) are recommended for screening, yet their performance in Vietnam remains unclear. This study evaluated and compared these indices in Vietnamese adults. Methods: A cross-sectional study was conducted at the Health Screening Department, University Medical Center Ho Chi Minh City (September 2024–January 2025). After exclusions, 290 adults undergoing routine check-ups with abdominal ultrasound were included. Clinical and laboratory data were collected to calculate TyG, TyG-BMI, TyG-WC, and FLI, and their diagnostic performance for MAFLD was compared using logistic regression and receiver operating characteristic (ROC) analysis, with area under the ROC curve (AUROC) and 95% confidence intervals (CIs). Results: Of 290 participants, 32.76% were diagnosed with MAFLD. Patients with MAFLD were older, more frequently male, and had higher body mass index (BMI), waist circumference (WC), blood pressure (BP), metabolic comorbidities, and abnormal biochemical parameters compared with non-MAFLD. The highest diagnostic performance was observed with TyG-BMI and FLI, both showing area under the receiver operating characteristic curve (AUROC) = 0.89, followed by TyG-WC (0.88) and TyG (0.82). In gender-stratified analysis, indices performed better in females; TyG-BMI achieved the highest AUROC of 0.91, comparable to FLI (0.90). Conclusions: TyG, TyG-BMI, TyG-WC, and FLI demonstrated excellent and comparable diagnostic accuracy for MAFLD, with superior performance in women. These indices represent practical, non-invasive tools for MAFLD screening in both clinical and community settings.
Full article
(This article belongs to the Special Issue Metabolic Health: The Interplay Between NAFLD, MAFLD, MASLD and Cardiovascular Disease)
►▼
Show Figures

Figure 1
Open AccessReview
Breast-Conserving Surgery in BRCA Mutation Carriers: A Paradigm Shift Toward Individualized, Multidisciplinary Care
by
Calogero Cipolla, Giuseppa Scandurra, Daniela Sambataro, Chiara Mesi, Martina Greco, Eleonora D’Agati, Vittorio Gebbia, Luca Giacomelli and Maria Rosaria Valerio
Life 2025, 15(11), 1701; https://doi.org/10.3390/life15111701 - 3 Nov 2025
Abstract
Breast cancer associated with BRCA1 and BRCA2 mutations presents unique therapeutic challenges, traditionally favoring mastectomy due to concerns over recurrence and new primaries. However, evolving evidence and advances in multimodal therapy have reshaped this paradigm, positioning breast-conserving surgery (BCS) as a viable option
[...] Read more.
Breast cancer associated with BRCA1 and BRCA2 mutations presents unique therapeutic challenges, traditionally favoring mastectomy due to concerns over recurrence and new primaries. However, evolving evidence and advances in multimodal therapy have reshaped this paradigm, positioning breast-conserving surgery (BCS) as a viable option for selected carriers. This narrative review synthesizes current data from meta-analyses, retrospective cohorts, and pivotal studies, including a multicenter analysis which affirmed oncologic equivalence between BCS and mastectomy when combined with radiotherapy and systemic therapy. While meta-analyses confirm higher local events following BCS, survival remains comparable, indicating that recurrence reflects genetic predisposition rather than surgical inadequacy. Optimized systemic treatments, including chemotherapy, endocrine therapy, risk-reducing salpingo-oophorectomy, and PARP inhibitors, further mitigate recurrence risk. Meanwhile, patient-centered outcomes favor BCS: studies consistently link it to improved body image, psychosocial well-being, and quality of life, especially for younger BRCA carriers. Fertility-preserving options remain viable, with evidence supporting the safety of pregnancy, breastfeeding, and assisted reproductive technologies in BRCA-mutated survivors. These findings support individualized surgical planning for BRCA carriers within multidisciplinary care, balancing oncologic safety, systemic strategies, and psychosocial priorities. BCS should be considered a standard option for well-selected patients in hereditary breast cancer management.
Full article
(This article belongs to the Special Issue New Insights into Breast Cancer: Current Controversies and Future Perspectives)
Open AccessArticle
Impact of Drinking Water Supplemented with Complex Acidifiers on Production Performance, Egg Quality, Physiological and Biochemical Indicators, and Microbial Flora of BIAN Chickens
by
Bochi Zhang, Liying Du, Tao Yu, Kai Zhang, Rui Zhao, Chunlei Yang and Xianyi Song
Life 2025, 15(11), 1700; https://doi.org/10.3390/life15111700 - 3 Nov 2025
Abstract
This study investigated the effects of dietary supplementation with composite acidifying agents containing 2-hydroxy-4-methylthiobutyric acid (≥30.0%), lactic acid (≥24.2%), and phosphoric acid (≥23.8%) on production performance, egg quality, serum biochemistry, intestinal health, and cecal microbiota in 300-day-old BIAN chickens. In a 42-day randomized
[...] Read more.
This study investigated the effects of dietary supplementation with composite acidifying agents containing 2-hydroxy-4-methylthiobutyric acid (≥30.0%), lactic acid (≥24.2%), and phosphoric acid (≥23.8%) on production performance, egg quality, serum biochemistry, intestinal health, and cecal microbiota in 300-day-old BIAN chickens. In a 42-day randomized trial, 900 laying hens were randomly allocated to three groups: the control group (basal diet with tap water), test group A (basal diet with 0.05% composite acidifier in drinking water), and test group B (basal diet with 0.20% composite acidifier in drinking water). The results demonstrated that test group B exhibited a significant 4.6% increase in average egg weight compared to the control (p = 0.029), while test group A showed enhanced Haugh unit values (p = 0.010) and eggshell strength (p = 0.010). Serum biochemical analysis revealed marked improvements in immune function, with test group B showing a 65.49% increase in globulin levels (p = 0.010) and 61.76% elevation in total antioxidant capacity (T-AOC) (p = 0.010). Intestinal digestive enzyme activities were significantly enhanced, particularly in test group A with a 61.73% increase in duodenal lipase activity (p = 0.010) and 37.43% elevation in jejunal amylase activity (p = 0.036). Morphological assessment demonstrated improved intestinal architecture in test group B, with a 26.02% reduction in crypt depth (p = 0.025) and a 44.53% increase in the villus-to-crypt ratio (p = 0.030). Microbiota analysis revealed dose-dependent modulation of cecal bacterial communities, with notable increases in beneficial genera including Akkermansia (from 1.8% to 7.2% in test group A) and Lachnospiraceae (from 4.7% to 9.7% in test group B) while maintaining core microbiota stability. Principal component analysis confirmed distinct microbial ecological niches created by acidifier supplementation. These findings demonstrate that composite acidifying agents effectively enhance egg production quality, immune status, digestive function, and gut health in BIAN chickens, supporting their potential as sustainable alternatives to antibiotic growth promoters in laying hen production systems.
Full article
(This article belongs to the Special Issue Advances in Livestock Breeding, Nutrition and Metabolism)
►▼
Show Figures

Figure 1
Open AccessSystematic Review
Effects of Body Weight Strength Training on Cognitive Function and Quality of Life in Healthy Older People: A Systematic Review of Randomized Controlled Trials
by
Álvaro Levín Catrilao, Bastián Parada-Flores, Pablo Aravena-Sagardia, Edgar Vásquez-Carrasco, Jordan Hernandez-Martinez, Felipe Caamaño-Navarrete, Carlos Arriagada-Hernandez, Cristian Sandoval, Tomás Herrera-Valenzuela, Braulio Henrique Magnani Branco and Pablo Valdés-Badilla
Life 2025, 15(11), 1698; https://doi.org/10.3390/life15111698 - 2 Nov 2025
Abstract
Objective: This systematic review evaluated the effects of body weight strength training (BWST) on cognitive function and health-related quality of life (HRQoL) in apparently healthy older people compared with active/inactive control groups. Methods: A literature search was conducted in six databases: PubMed, Web
[...] Read more.
Objective: This systematic review evaluated the effects of body weight strength training (BWST) on cognitive function and health-related quality of life (HRQoL) in apparently healthy older people compared with active/inactive control groups. Methods: A literature search was conducted in six databases: PubMed, Web of Science, Scopus, ScienceDirect, EBSCOhost, and PsycINFO. The PRISMA, TESTEX, RoB 2, and GRADEpro tools were used to assess the methodological quality and certainty of evidence. The protocol was registered in PROSPERO (code: CRD42024623038). Results: Among the 27,241 records, 9 randomized controlled trials involving 682 (85% women) apparently healthy older people were included. Compared with the active/inactive control groups, the BWST resulted in significant improvements in orientation to place, language, visuospatial ability, processing speed, attention, and short-term memory. Within-group improvements were observed in general cognitive function and health-related anxiety scores in both the BWST and active control groups. The calculation and set shifting improved only within the BWST group. Conclusions: The individual results of the RCTs suggest that BWST may have potential effects on cognitive function and HRQoL in apparently healthy older people. Nevertheless, the certainty of evidence was insufficient to support definitive recommendations. Therefore, further high-quality studies are needed to establish solid conclusions.
Full article
(This article belongs to the Section Physiology and Pathology)
►▼
Show Figures

Figure 1
Open AccessReview
Therapeutic Potential of Ishige okamurae Yendo as a Multi-Target Inhibitor Against Dementia Symptoms
by
Oh Yun Kwon and Seung Ho Lee
Life 2025, 15(11), 1699; https://doi.org/10.3390/life15111699 - 1 Nov 2025
Abstract
Ishige okamurae Yendo (I. okamurae) is a brown macroalga with diverse biological activities. Recently, its ameliorative effects against dementia progression have been demonstrated in various in vitro and in vivo models of Alzheimer’s disease (AD), glutamate excitotoxicity, and bacterial-driven neuroinflammation. I.
[...] Read more.
Ishige okamurae Yendo (I. okamurae) is a brown macroalga with diverse biological activities. Recently, its ameliorative effects against dementia progression have been demonstrated in various in vitro and in vivo models of Alzheimer’s disease (AD), glutamate excitotoxicity, and bacterial-driven neuroinflammation. I. okamurae extract (IOE) inhibited AD progression by regulating amyloid beta–induced neuronal death and cognitive impairments. Moreover, IOE attenuated glutamate-induced neurodegeneration by modulating the mitogen-activated protein kinases/Nrf2/heme oxygenase-1 signaling pathway. Furthermore, IOE effectively suppressed lipopolysaccharide-mediated neuroinflammation and memory deficits by downregulating the Toll-like receptor 4/MyD88-dependent signaling pathway. Collectively, these findings highlight the potential of IOE as a natural multi-target, anti-dementia agent. In this review, we summarize the neuroprotective and cognition-enhancing properties of IOE, discuss the molecular mechanisms underlying its action, and consider the advantages of I. okamurae as a promising natural resource for effective therapeutic developments that are capable of targeting multiple pathogenic causes of dementia.
Full article
(This article belongs to the Special Issue Therapeutic Effects of Natural Products on Human Diseases: 2nd Edition)
►▼
Show Figures

Figure 1
Open AccessArticle
Beyond Daily Values: Are Day-to-Day and Albumin-Adjusted Ratios of IL-6, PCT, and CRP Better Predictors of Ventilator-Associated Pneumonia?
by
Tobias Bexten, Golo-Sung Haarmeier, Johann Klein, Holger A. Lindner, Chaimae Rahali and Verena Schneider-Lindner
Life 2025, 15(11), 1697; https://doi.org/10.3390/life15111697 - 1 Nov 2025
Abstract
Background: Ventilator-associated pneumonia (VAP) is a frequent complication in neurosurgical intensive care patients. This leads to prolonged mechanical ventilation, increased 30-day mortality rates, and extended hospital stays. However, early diagnosis remains a challenge. Biomarkers, such as IL-6, PCT, and CRP, are considered a
[...] Read more.
Background: Ventilator-associated pneumonia (VAP) is a frequent complication in neurosurgical intensive care patients. This leads to prolonged mechanical ventilation, increased 30-day mortality rates, and extended hospital stays. However, early diagnosis remains a challenge. Biomarkers, such as IL-6, PCT, and CRP, are considered a cornerstone for recognizing VAP and initiating early treatment. Only a very limited number of studies have compared IL-6, PCT, and CRP, focusing on day-to-day dynamics and their albumin ratios. Therefore, we investigated whether, compared with their daily levels, the day-to-day dynamics and albumin-adjusted ratios of IL-6, PCT, and CRP offer improved diagnostic value for VAP. Second, we investigated these biomarkers in patients treated for VAP who did not meet the criteria for VAP. Methods: In this exploratory, matched case–control study, we investigated 171 neurosurgical ICU patients. Daily biomarker levels, their dynamics, and ratios to serum albumin were assessed beginning four days before VAP. Logistic regression and receiver operating curve (ROC) analyses were performed to evaluate the association between each biomarker and VAP. Results: IL-6 and its day-to-day dynamics demonstrated the largest differences between VAP patients and nonVAP patients (r = 0.631; r = 0.452) and were associated with VAP, yielding AUCs of 0.816 and 0.726, respectively. In contrast, for PCT, we did not demonstrate any associative utility, whereas CRP showed a significant, moderate effect size on the day of VAP occurrence (p = 0.015 *; r = 0.351). We could not demonstrate any superiority in the day-to-day dynamics or the albumin-adjusted ratios compared to the daily values. For patients who were treated for VAP without fulfilling the criteria for biomarkers, we did not observe any significant difference from nonVAP patients.
Full article
(This article belongs to the Special Issue Pathology, Diagnosis, and Treatments of Airway Diseases)
►▼
Show Figures

Figure 1
Open AccessArticle
A Novel Approach to Assessing In-Hospital Mortality After On-Pump Aortic Valve Replacement
by
Anca Drăgan, Adrian Ştefan Drăgan and Ovidiu Ştiru
Life 2025, 15(11), 1696; https://doi.org/10.3390/life15111696 - 31 Oct 2025
Abstract
Background: Surgical aortic valve replacement (SAVR) is the main treatment for severe aortic valve disease, the most common valvular heart disease worldwide. Methods: We evaluated the in-hospital mortality risk factors and predictors following on-pump SAVR. We retrospectively reviewed data from consecutive patients treated
[...] Read more.
Background: Surgical aortic valve replacement (SAVR) is the main treatment for severe aortic valve disease, the most common valvular heart disease worldwide. Methods: We evaluated the in-hospital mortality risk factors and predictors following on-pump SAVR. We retrospectively reviewed data from consecutive patients treated at a tertiary center from 2022 to 2024, focusing on routine hematological data and inflammatory indexes, alongside established factors. Results: Postoperative vasoactive-inotropic score (VIS) (OR 1.058, CI 95%: 1.007–1.112), platelet count (OR 1.033, CI 95%: 1.002–1.064), lymphocyte counts (OR 3.532, CI 95%: 1.507–8.278), and perioperative fresh frozen plasma transfusion (OR 1.335, CI 95%: 1.068–1.669) were independent risk factors for SAVR in-hospital mortality. VIS best predicted the endpoint (AUC 0.929, p = 0.001). Postoperative platelet count and platelet-to-lymphocytes ratio (PLR) outperformed the additive EuroSCORE in predicting the outcome, but not EuroSCORE II. Conclusions: Although EuroSCORE II remained superior to inflammatory indexes in predicting in-hospital death, the dynamic postoperative monitoring provided added value beyond static preoperative risk scores. This dynamic approach supported personalized monitoring and targeted therapeutic interventions. Postoperative VIS, platelet, lymphocyte counts, and PLR represent dynamic, low-cost predictors of in-hospital mortality after on-pump SAVR, offering a complementary value to EuroSCORE II–based models.
Full article
(This article belongs to the Special Issue Advancements in Postoperative Management of Patients After Surgery)
►▼
Show Figures

Figure 1
Open AccessArticle
Low-Cost Protocol for Quantitative Measurement of Streptococcus salivarius in Human Saliva
by
Flavia-Cristina Al-Akel, Lacramioara Eliza Chiperi, Krisztina Eszter Vas, Edit Szekely, Claudia Raluca Mariean, Corina Eugenia Budin and Anca Bacarea
Life 2025, 15(11), 1695; https://doi.org/10.3390/life15111695 - 31 Oct 2025
Abstract
Streptococcus salivarius (S. salivarius) is a prominent oral commensal bacterium with probiotic potential and relevance to both oral and systemic health. Accurate and accessible methods for quantitative measurement of this species are needed to support microbiota studies and clinical interventions. We
[...] Read more.
Streptococcus salivarius (S. salivarius) is a prominent oral commensal bacterium with probiotic potential and relevance to both oral and systemic health. Accurate and accessible methods for quantitative measurement of this species are needed to support microbiota studies and clinical interventions. We describe a simple, low-cost, culture-based method for quantifying S. salivarius in human saliva using Mitis-Salivarius Agar. Saliva samples from 18 healthy adult volunteers were analyzed through serial dilutions and selective plating. CFU (colony forming unit)/mL were calculated after 24 and 48 h incubation. The method proved reliable for quantifying S. salivarius in concentrations ranging from 5.8 × 105 to 6.1 × 108 CFU/mL. Although Mitis-Salivarius Agar is a standard medium, we demonstrate its systematic validation and optimization for human saliva in a low-resource clinical setting, where molecular tools are often unavailable.
Full article
(This article belongs to the Section Microbiology)
►▼
Show Figures
Figure 1
Open AccessCorrection
Correction: Zheng et al. HMGA1 and FOXM1 Cooperate to Promote G2/M Cell Cycle Progression in Cancer Cells. Life 2023, 13, 1225
by
Qingfang Zheng, Ziyang Luo, Mingjun Xu, Shazhou Ye, Yuxin Lei and Yang Xi
Life 2025, 15(11), 1694; https://doi.org/10.3390/life15111694 - 31 Oct 2025
Abstract
In the original publication [...]
Full article
(This article belongs to the Section Cell Biology and Tissue Engineering)
►▼
Show Figures

Figure 1
Open AccessSystematic Review
The Role of CT Perfusion in the Evaluation and Management of Acute Ischemic Stroke—A Systematic Review
by
Rares C. Bobe, Roxana E. Coroiu, Adelina E. Cirstian, Camelia I. Cristescu, Diana A. Pepelea and Rosana M. Manea
Life 2025, 15(11), 1693; https://doi.org/10.3390/life15111693 - 31 Oct 2025
Abstract
Background: CT perfusion (CTP) is increasingly used in the evaluation of acute ischemic stroke (AIS) and may complement non-contrast CT (NCCT) and CT angiography (CTA). This review aimed to assess the role of CTP in patient selection for reperfusion therapy, its prognostic value,
[...] Read more.
Background: CT perfusion (CTP) is increasingly used in the evaluation of acute ischemic stroke (AIS) and may complement non-contrast CT (NCCT) and CT angiography (CTA). This review aimed to assess the role of CTP in patient selection for reperfusion therapy, its prognostic value, and the influence of technical factors, collateral assessment, and post-processing software. Methods: A literature search of PubMed, DOAJ, and Google Scholar (2014–2025) identified 119 articles; after screening, 39 met inclusion criteria. Only studies on adult AIS patients investigated with CTP were included. Data were synthesized across eight thematic categories: core/penumbra estimation, prognosis, treatment selection, collateral assessment, software validation, technical parameters, reliability, and safety. Results: CTP improved identification of infarct core, penumbra, and collateral status, aiding patient selection for endovascular therapy, particularly beyond 6 h. Limitations included variability in tissue thresholds, “ghost infarct core,” and differences across software. Technical advances, such as “one-stop-shop” protocols and low-kV acquisition, reduced treatment delays and radiation. Reliability studies showed CTP to be less accurate than diffusion-weighted MRI, while safety analyses confirmed a low risk of contrast-induced nephropathy. Conclusions: CTP enhances patient stratification and outcome prediction, supporting individualized treatment strategies. Standardization of protocols and validation of software remain necessary before CTP can serve as a reliable alternative to MRI-DWI.
Full article
(This article belongs to the Special Issue Advances in Endovascular Therapies and Acute Stroke Management)
►▼
Show Figures

Figure 1
Open AccessArticle
Complex Characterization of Cerebral Vasoreactivity in Internal Carotid Artery Stenotic Patients with Transcranial Doppler Sonography
by
Hanga Pál, Rita Magyar-Stang, Borbála Csányi, Anna Gaál, Zsuzsanna Mihály, Zsófia Czinege, Péter Sótonyi, Tamás Horváth, Balázs Dobi, Dániel Bereczki, Akos Koller and Róbert Debreczeni
Life 2025, 15(11), 1692; https://doi.org/10.3390/life15111692 - 30 Oct 2025
Abstract
Background and Aims: Decreased cerebrovascular reactivity (CVR) in patients with significant internal carotid artery stenosis (ICAS ≥ 70%) is an independent risk factor for cerebral infarction. To evaluate CVR, changes in cerebral perfusion pressure and blood flow velocity (BFV) of the middle cerebral
[...] Read more.
Background and Aims: Decreased cerebrovascular reactivity (CVR) in patients with significant internal carotid artery stenosis (ICAS ≥ 70%) is an independent risk factor for cerebral infarction. To evaluate CVR, changes in cerebral perfusion pressure and blood flow velocity (BFV) of the middle cerebral artery (MCA) can be estimated by CO2- (hyperventilation—HV and breath-holding—BH) and pressure–flow-based (Common Carotid Artery Compression—CCC and Valsalva Maneuver—VM) stimuli. We used a multimodal approach to characterize CVR in patients before carotid endarterectomy (CEA). Methods: HV, BH, CCC, and VM tests were performed on 31, 26, and 34 patients. BFV of MCAs was monitored by transcranial Doppler, and continuous arterial blood pressure was registered non-invasively. CVR was compared between the operated significantly stenotic and the contralateral sides. Results: The extent of HV- and BH-induced CVR was similar, but the time to the lowest HV-induced BFV was shorter on the side with significant ICAS. The response to CCC was sensitive to hemodynamic asymmetry in the transient hyperemic response ratio and in the cumulative change in the (mean arterial blood pressure)/(mean BFV) ratio. In VM, the slope of BFV increased in the ascending (2b) phase, and the time to overshoot correlated with the side of the stenosis. Conclusions: These results suggest that in patients with significant ICAS, in addition to CO2 reactivity measurements, a more complex estimation of CVR, by using hemodynamic tests (CCC and VM), should also be used to better quantify cerebral ischemic risk.
Full article
(This article belongs to the Special Issue Regulation of Cerebrovascular Resistance in Health and Disease: From Molecules to Humans)
►▼
Show Figures

Figure 1
Open AccessArticle
Placental Volume, Vascularization, and Epigenetic Modifications in Obesity and Gestational Diabetes: A 3-D Ultrasound and Molecular Analysis
by
Balint Kolcsar, Kata Kira Kemeny, Zoltan Kozinszky, Eszter Ducza and Andrea Suranyi
Life 2025, 15(11), 1691; https://doi.org/10.3390/life15111691 - 30 Oct 2025
Abstract
Background: Obesity and gestational diabetes mellitus (GDM) are the most common metabolic conditions that have an unfavorable impact on maternal and fetal health. Maternal obesity and GDM are often associated with placental dysfunction and structural alterations. The apelin receptor (APLNR), vascular endothelial growth
[...] Read more.
Background: Obesity and gestational diabetes mellitus (GDM) are the most common metabolic conditions that have an unfavorable impact on maternal and fetal health. Maternal obesity and GDM are often associated with placental dysfunction and structural alterations. The apelin receptor (APLNR), vascular endothelial growth factor (VEGF), leptin, and DNA methylation play crucial roles in placental function. We aimed to investigate the placental volume and vascularization, and to determine the changes in these markers in obese and GDM mothers. Material and Methods: In our study, we investigated the human placenta (n = 48) at term. The placental structural analyses on volume and vascularization were conducted using three-dimensional ultrasound before labor. Placental APLNR expression was determined using RT-PCR, and leptin and VEGF concentrations using ELISA in placental tissues. Global DNA methylation was measured using colometric assay. Results: The age of GDM mothers was significantly higher than that of normal and obese mothers. The gestation length of GDM mothers was significantly shorter than that of normal and obese mothers. The placental volume was significantly higher in obese and GDM cases compared with normal cases. Vascularization indices (VI, FI, VFI) were significantly depressed in GDM and obesity. In the case of biomarker studies, APLNR, leptin, and VEGF showed similar decreases in obese and GDM placentas. Based on our results, the effect of GDM, not obesity, was more pronounced for these biomarkers. VEGF reduction correlates with three-dimensional placental vascularity studies. The DNA methylation was significantly elevated in both GDM and obese placental samples, while the GDM effect was more pronounced. Conclusions: This study is the first to demonstrate structural alterations of the placenta using placental tissue biomarkers in obesity and gestational diabetes mellitus (GDM). We found that both GDM and obesity affect placental volume and vascularity, as indicated by reduced leptin and VEGF levels, presumably mediated by epigenetic effects. Our findings may provide a novel therapeutic target for improving abnormal placental function caused by GDM and obesity.
Full article
(This article belongs to the Special Issue Prevention, Diagnosis, and Treatment of Gestational Diseases)
►▼
Show Figures

Figure 1
Open AccessArticle
Assessment and Rehabilitation in Cervical Radiculopathy—Efficacy of Structured Program with or Without Neurotrophic Agents
by
Rodica Magdalena Trăistaru, Kamal Constantin Kamal, Diana Kamal, Diana-Lidia Tache-Codreanu and Adina Maria Kamal
Life 2025, 15(11), 1690; https://doi.org/10.3390/life15111690 - 30 Oct 2025
Abstract
Chronic cervical radiculopathy (CR) is a common cause of pain and disability in adults. The primary objective of our study was to evaluate the efficacy of a structured, multimodal rehabilitation program, with or without adjunct neurotrophic supplementation, in chronic cervical radiculopathy; secondarily, this
[...] Read more.
Chronic cervical radiculopathy (CR) is a common cause of pain and disability in adults. The primary objective of our study was to evaluate the efficacy of a structured, multimodal rehabilitation program, with or without adjunct neurotrophic supplementation, in chronic cervical radiculopathy; secondarily, this study investigates which patients are most likely to benefit from neurotrophic supplementation and aims to assess effects on pain, cervical mobility, disability, and daily activities to guide individualized care. Patients and Methods: In this prospective, randomized controlled trial, 82 patients with chronic CR were allocated to a study group (SG, n = 42) receiving a three-month multimodal rehabilitation program plus daily neurotrophic supplementation (named PHSD) or a control group (CG, n = 40) receiving the same rehabilitation alone. Outcome measures included the Visual Analogue Scale (VAS), Neck Disability Index (NDI), cervical mobility indexes (CSI—Chin-Sternum Index; OWI—Occiput-Wall Index; TAI—Tragus-Acromion Index), and Katz ADL (Activity of Daily Living) Index, assessed at baseline and after three months. Results: Both groups showed significant improvements, but the SG demonstrated greater reductions in pain (median VAS change: 8.16 ± 0.72 vs. 5.11 ± 0.70, p < 0.001) and disability (mean NDI change: 24.71 ± 5.13 vs. 20.90 ± 4.49, p < 0.001). Cervical mobility indexes improved in both groups, with larger gains in the SG (p < 0.01), supporting the potential benefits of adding neurotrophic supplementation. Conclusions: A structured multimodal rehabilitation program significantly improves pain, mobility, and disability in chronic CR, while combining it with PHSD may enhance these effects. Further randomized trials are needed to confirm these findings and establish standardized conservative treatment protocols.
Full article
(This article belongs to the Special Issue Orthopedic Disease Treatment and Management: Innovations, Challenges, and Future Directions)
►▼
Show Figures

Figure 1
Open AccessArticle
Virulence Plasmid Modulates Glucose-Mediated Biofilm Regulation in Yersinia enterocolitica
by
Yunah Oh and Tae-Jong Kim
Life 2025, 15(11), 1689; https://doi.org/10.3390/life15111689 - 30 Oct 2025
Abstract
Yersinia enterocolitica is a foodborne pathogen capable of biofilm formation and virulence modulation in response to environmental signals. Among these, glucose—present at physiologically relevant concentrations in the human body—may serve as a regulatory cue affecting infection-associated pathways, including those governed by the pYV
[...] Read more.
Yersinia enterocolitica is a foodborne pathogen capable of biofilm formation and virulence modulation in response to environmental signals. Among these, glucose—present at physiologically relevant concentrations in the human body—may serve as a regulatory cue affecting infection-associated pathways, including those governed by the pYV virulence plasmid. Although the role of glucose has been investigated under host-mimicking conditions, its impact in non-host environments remains poorly understood. This study was designed to evaluate the glucose-dependent physiological responses of two isogenic Y. enterocolitica strains, KT0001 (pYV-negative) and KT0003 (pYV-positive), under non-host conditions (26 °C). Both strains were cultured in TYE medium containing 0–3% glucose. Comparative analyses were conducted under identical in vitro conditions to elucidate plasmid-associated phenotypic differences. Glucose elicited markedly divergent responses. In KT0001, growth remained unaffected; however, biofilm formation declined by 77.7%, accompanied by a 90% reduction in surface hydrophobicity, a 40% decrease in motility, and a 59% drop in intracellular cyclic AMP—suggesting classical carbon catabolite repression. Conversely, KT0003 exhibited 86% growth inhibition but maintained biofilm levels. This was associated with substantial extracellular polymeric substance induction (~20-fold increase in polysaccharides and ~4.7-fold in extracellular DNA) and nearly fivefold elevation in cyclic AMP levels, despite concurrent decreases in motility (64%) and hydrophobicity (40%). These findings indicate that glucose functions as a strain-specific modulator in Y. enterocolitica. In particular, KT0003’s response suggests that the pYV plasmid enables the bacterium to interpret glucose as a host-associated cue, even under non-host conditions, potentially initiating virulence-related adaptations prior to host contact.
Full article
(This article belongs to the Section Microbiology)
►▼
Show Figures

Figure 1
Journal Menu
► ▼ Journal Menu-
- Life Home
- Aims & Scope
- Editorial Board
- Reviewer Board
- Topical Advisory Panel
- Instructions for Authors
- Special Issues
- Topics
- Sections & Collections
- Article Processing Charge
- Indexing & Archiving
- Editor’s Choice Articles
- Most Cited & Viewed
- Journal Statistics
- Journal History
- Journal Awards
- Society Collaborations
- Conferences
- Editorial Office
Journal Browser
► ▼ Journal BrowserHighly Accessed Articles
Latest Books
E-Mail Alert
News
Topics
Topic in
Animals, Cells, Life, Veterinary Sciences
Application of Animal Models: From Physiology to Pathology
Topic Editors: Juan Carlos Illera del Portal, Sara Cáceres Ramos, Felisbina Luisa QueirogaDeadline: 20 December 2025
Topic in
Dentistry Journal, JCM, Materials, Biomedicines, Life
Medical and Dental Care, Photobiomodulation and Photomedicine
Topic Editors: Samir Nammour, Chukuka Samuel Enwemeka, Aldo Brugnera JuniorDeadline: 31 December 2025
Topic in
Animals, Arthropoda, Diversity, Insects, Life, Pathogens
Arthropod Biodiversity: Ecological and Functional Aspects, 2nd Edition
Topic Editors: Paolo Solari, Roberto M. Crnjar, Anita Giglio, Gianluca TettamantiDeadline: 31 January 2026
Topic in
Antioxidants, Cancers, Gastroenterology Insights, Life, Nutrients
Oxidative Stress and Diet: The Health Implications of Advanced Glycation and Lipid Oxidation End-Products
Topic Editors: Joseph Kanner, Ron KohenDeadline: 31 March 2026
Conferences
Special Issues
Special Issue in
Life
Breaking the Code: How Genome Sequencing Is Revolutionizing the Diagnosis of Rare Diseases
Guest Editors: Massimiliano Chetta, Nenad BukvicDeadline: 6 November 2025
Special Issue in
Life
Advancing Plant Resilience: Genetics and Agronomy
Guest Editors: Meng Jiang, Ruiqing Li, Ning XuDeadline: 14 November 2025
Special Issue in
Life
Placental Spectrum Disorders and Gynecological Oncology
Guest Editor: Gianluca Raffaello DamianiDeadline: 15 November 2025
Special Issue in
Life
Plant-Derived Natural Products and Their Biomedical Properties: 2nd Edition
Guest Editors: Efstathia Papada, Charalampia AmerikanouDeadline: 15 November 2025
Topical Collections
Topical Collection in
Life
Biodiversity and Ecology of Fungi in Terrestrial and Marine Ecosystems
Collection Editors: Armin Mešić, Ivana Kušan
Topical Collection in
Life
State of the Art in Plant Science
Collection Editors: Kousuke Hanada, Yoshiteru Noutoshi
Topical Collection in
Life
Bacterial Infections, Treatment and Antibiotic Resistance
Collection Editor: Milan Kolář



